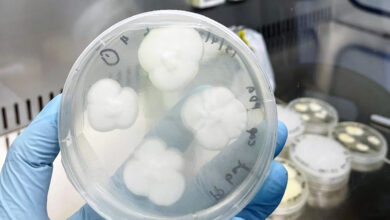

Investigación revela que la IA procesa información como los humanos
Estudio revela que modelos de IA como ChatGPT y Gemini Pro Vision organizan información de manera espontánea, imitando el procesamiento conceptual humano
Investigaciones recientes han revelado que modelos de lenguaje de inteligencia artificial (IA), como ChatGPT de OpenAI y Gemini Pro Vision de Google, muestran capacidades que imitan el procesamiento conceptual humano. Un estudio realizado por la Academia China de Ciencias y la Universidad Tecnológica del Sur de China descubrió que estos sistemas pueden organizar información de manera espontánea, sin haber sido entrenados específicamente para ello.
Los científicos sometieron a estos modelos a una prueba conocida como “prueba del extraño”, donde se les pidió clasificar objetos en 66 dimensiones conceptuales. Sorprendentemente, las representaciones resultantes fueron interpretables y compartían similitudes con las estructuras cognitivas humanas. Esto sugiere que, aunque las representaciones de objetos en los modelos de IA no son idénticas a las humanas, comparten aspectos fundamentales del conocimiento conceptual humano.
Estos hallazgos, publicados en la revista Nature Machine Intelligence, desafían la suposición de que los sistemas de IA se limitan a imitar respuestas mediante el reconocimiento de patrones. Por el contrario, indican que estos modelos desarrollan representaciones conceptuales que reflejan aspectos clave del conocimiento humano.
Los investigadores esperan que estos avances contribuyan al desarrollo de sistemas cognitivos artificiales más similares a los humanos, capaces de colaborar de manera más efectiva con las personas. Este estudio se suma a otros esfuerzos en curso para crear inteligencias artificiales que no solo procesen datos, sino que también comprendan y razonen de manera más humana.